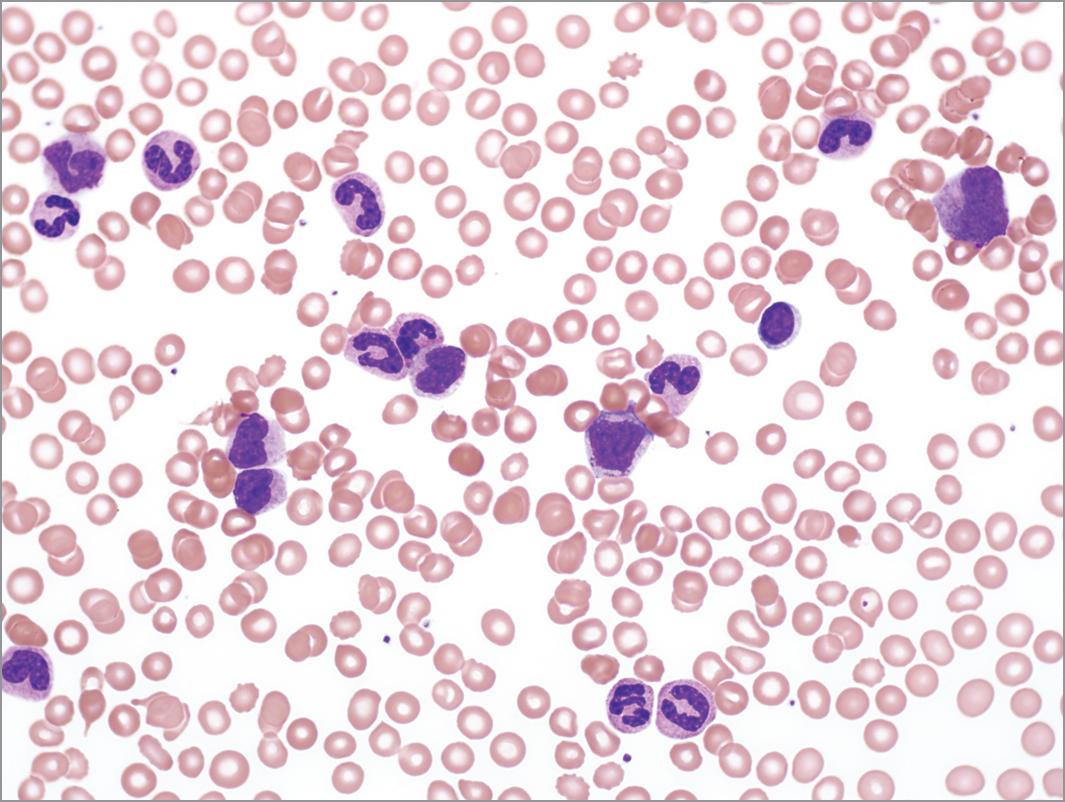
鱼病毒病解决方案,热带淡水鱼鱼病用药一览表

病毒性鱼病与治疗-鱼类常见疾病与预防系列
病毒是一种比细菌还小,只能在细胞内生长繁殖的非细胞形态的微生物,由它们引起的鱼病日益增多,并给渔业生产造成严重损失。危害较大的病毒有出血病和痘疮病。

病毒性鱼病与治疗-鱼类常见疾病与预防系列
1.出血病
它是严重危害当年草鱼种的一种急性传染病,发病率高,可引起草鱼种大量死亡。
[病原]是一种疱疹病毒,暂名为草鱼疱疹病毒,简称HVGC。
[症状]主要是出血。根据病鱼表现症状及病理变化,可分为三种类型:红肌肉型、 红鳍红鳃盖型和肠炎型。
[流行特点]主要流行于我国南方主要养龟区,在北京也偶有发生。8月中、下旬为 发病髙峰期,9月中旬后逐渐结束。同池中的鲢、鳙、鲤不发病,主要感染7厘米以上草鱼种。
[防治方法]
注射草鱼出血病疫苗。投喂大黄药饵,每百千克鱼用0.5〜2千克做成颗粒饵料,投喂4〜5天,并且用硫酸铜全池泼洒,使池水浓度达0.7毫克/升,连续两次。

病毒性鱼病与治疗-鱼类常见疾病与预防系列
2.痘疮病
[病原]疮疹病毒。
[症状]皮肤表面有许多石蜡状增生物,发病初期体表出现乳白色小斑点,随着病情发展,逐渐增大变厚,并蔓延全身,增生物略呈淡红或灰白色,可高出体表1〜2毫米。
[流行特点]在欧洲,此病是鲤鱼主要病害之一。我国在网箱、池塘养鲤中均有发生,尤其在水质较为污染的水域中更易感染,主要流行季节为9〜10月,但危害不大, 主要感染1龄以上鲤鱼。
[防治方法]
氯霉素注射和浸洗混合法:肌肉注射,每尾成鱼用12.5毫克,然后放入0.25毫克/升氯霉素液中浸洗。移至含氧量高的清水中,增生物可自然脱落。
预告下次会介绍《10种细菌性鱼病的防治》,喜欢的朋友可以点击关注。
注:本文原创,如转载请注明:作者‘奥克丹蒋经理’
上网搜索:‘奥克丹蒋经理’ 索取水产养殖水质管理资料。
病毒性鱼病与治疗-鱼类常见疾病与预防系列